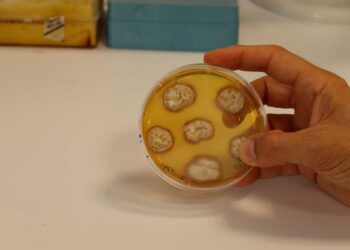
Identifican un mecanismo necesario para que las plantas hagan un mejor uso de los nutrientes

Una ecografía que da esperanza: la cría de tapir malayo del Bioparc Fuengirola avanza «perfectamente»
Hace unas semanas conocimos la gran noticia de que la hembra de tapir malayo que se encuentra en Bioparc Fuengirola...
Leer másCientíficos de la UMA aportan una posible solución ante la falta de agua en Málaga
Optimizar la explotación del agua subterránea en Málaga es el objetivo principal del 'iSAT' --Sistema de Alerta Temprana Inteligente--, la...
Leer másMART, la escudería de la UMA, vuelve a poner el nombre de Málaga en el escaparate internacional
MART (Málaga Racing Team), la escudería de la Universidad de Málaga, ha alcanzado el tercer puesto en la segunda edición...
Leer másDaniel Jurado, profesor de Estepona, finalista a mejor docente de España 2024: «Siento orgullo y responsabilidad»
Dos meses atrás un profesor de Estepona acaparaba multitud de medios provinciales al conocer que estaba entre los nominados a...
Leer másInvestigadores andaluces desarrollan soluciones con extractos de cebolla para combatir plagas en el olivo
Un equipo de investigadores andaluces ha desarrollado soluciones innovadoras para combatir plagas del olivo a través de extractos de cebolla...
Leer másLa Churrería Ramón de Marbella incluida en el mapa de las 10 mejores churrerías de España
"Un clásico de la Costa del Sol desde 1941". Así definen en The Gourmet Journal a la Churrería Ramón de...
Leer másInvestigadores identifican una diana potencial para abordar una grave enfermedad cardíaca en pacientes diabéticos
Investigadores del Centro de Investigación Biomédica en Red (CIBER) han logrado identificar una diana potencial para abordar en pacientes diabéticos...
Leer másIdentifican un mecanismo necesario para que las plantas hagan un mejor uso de los nutrientes
Investigadores del IHSM La Mayora han identificado el modulador clave 'RALF22' con el que las plantas detectan ciertas sustancias emitidas...
Leer másEl marbellí Luis Ángel Maté recibe el Premio ‘Gino Mäder’ por sus acciones solidarias en la gala Velo d’Or de París
Luis Ángel Maté, protagonista en la última edición de ONCESOLES por su retirada como profesional del ciclismo, ha sido el...
Leer másLas universidades andaluzas están entre las mejores del mundo en 37 especialidades científicas
El sistema universitario andaluz está compuesto por nueve instituciones académicas públicas con su propio personal docente e investigador, además de...
Leer más